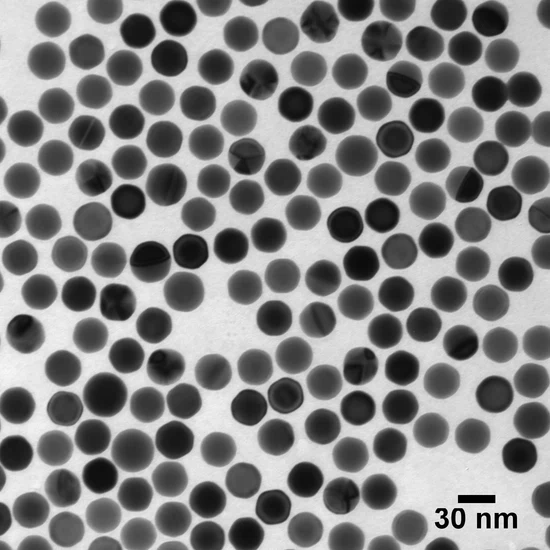

HOME
keyboard_arrow_right
新聞集錦
keyboard_arrow_right
產品資訊
keyboard_arrow_right
超均勻金奈米粒子&粒子數標準品全面上市- 強化奈米分析、診斷與生醫研發的可靠度
產品資訊
2025/11/25
超均勻金奈米粒子&粒子數標準品全面上市- 強化奈米分析、診斷與生醫研發的可靠度
Ultra Uniform 金奈米球:完美球形、超高均一性,五種粒徑選擇
Ultra Uniform 金奈米球具備近乎完美的球形結構、極窄的粒徑分布及高度穩定的電漿共振光學特性,提供 10、20、30、50、100 nm 五種粒徑規格。
其優異的一致性與表面穩定度讓其成為以下應用的理想選擇:
- 尺寸與粒子數參考標準
- 各類生物標記(biolabeling)
- 奈米醫學與生醫材料研究
- 奈米藥物傳遞與配方開發
金奈米粒子數標準品:高精度奈米量測的最佳參考物
此系列專為精準粒子分析所設計,提供 30、50、100 nm 三種粒徑,產品以固定且可追溯的粒子數濃度(0.8–1.2 × 10⁸ particles/mL)嚴格控管品質,適用於多種奈米分析平台,包括:
- sp-ICP-MS
- NTA(Nanoparticle Tracking Analysis)
- TRPS(Tunable Resistive Pulse Sensing)
所有產品皆附有批次專屬 Certificate of Analysis(CoA),TEM、DLS、Zeta Potential、UV-Vis
nanoComposix 亦提供客製化粒徑、濃度與表面修飾選項,並由技術團隊提供專業諮詢,協助客戶打造最符合其研究方向、產品策略與應用情境的奈米材料組合。
如需進一步了解產品資訊,歡迎詳閱<產品資訊>或來電由我們為您服務!